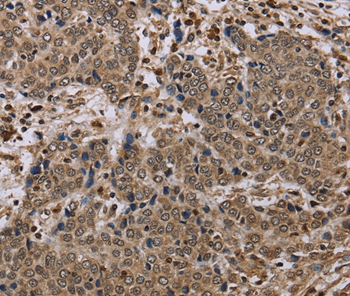

NALP4 / NLRP4 Antibody (aa139-157)
LS-C148285
ApplicationsImmunoPrecipitation, Western Blot, ImmunoHistoChemistry, ImmunoHistoChemistry Frozen, ImmunoHistoChemistry Paraffin
Product group Antibodies
TargetNLRP4
Overview
- SupplierLifeSpan BioSciences
- Product NameNALP4 / NLRP4 Antibody (aa139-157)
- Delivery Days Customer23
- ApplicationsImmunoPrecipitation, Western Blot, ImmunoHistoChemistry, ImmunoHistoChemistry Frozen, ImmunoHistoChemistry Paraffin
- Applications SupplierIHC, IHC-Fr, IHC-P (1:1000 - 1:5000), IP (1:50 - 1:200), WB (1:1000 - 1:2000)
- CertificationResearch Use Only
- ClonalityPolyclonal
- ConjugateUnconjugated
- Estimated Purity...
- Gene ID147945
- Target nameNLRP4
- Target descriptionNLR family pyrin domain containing 4
- Target synonymscancer/testis antigen 58; CLR19.5; CT58; NACHT, leucine rich repeat and PYD containing 4; NACHT, LRR and PYD domains-containing protein 4; NALP4; nucleotide-binding oligomerization domain, leucine rich repeat and pyrin domain containing 4; PAAD and NACHT-containing protein 2; PAN2; PYPAF4; PYRIN and NACHT-containing protein 2; PYRIN-containing APAF1-like protein 4; ribonuclease inhibitor 2; RNH2
- HostRabbit
- Storage Instruction-20°C
- UNSPSC12352203